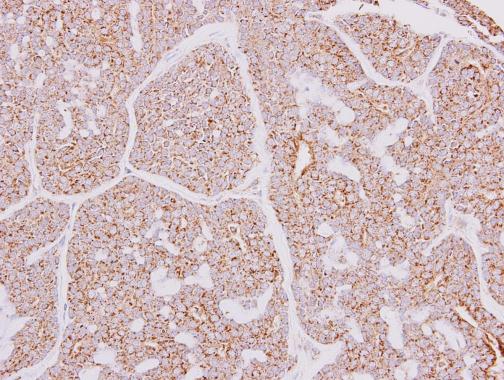
产品封面图

相关产品推荐更多 >
万千商家帮你免费找货
0 人在求购买到急需产品
- 详细信息
- 文献和实验
- 技术资料
- 免疫原:
Recombinant protein encompassing a sequence within the center region of human CARD10. The exact sequence is proprietary.
- 亚型:
IgG
- 形态:
Liquid
- 保存条件:
Store as concentrated solution. Centrifuge briefly prior to opening vial. For short-term storage (1-2 weeks), store at 4ºC. For long-term storage, aliquot and store at -20ºC or below. Avoid multiple freeze-thaw cycles.
- 克隆性:
Polyclonal
- 标记物:
Unconjugated
- 适应物种:
Human, Mouse
- 保质期:
12 months from the shipping date of the product.
- 抗原来源:
Human
- 目录编号:
GTX111222
- 级别:
Primary Antibodies
- 库存:
Available
- 供应商:
GeneTex
- 宿主:
Rabbit
- 应用范围:
WB, IHC-P, IHC-Fr
- 浓度:
1.25 mg/ml (Please refer to the vial label for the specific concentration.)
- 靶点:
CARD10
- 抗体英文名:
CARD10 antibody [N2C1], Internal
- 抗体名:
CARD10 抗体 [N2C1], Internal
- 规格:
100 μl/25 μl
| 规格: | 100 μl | 产品价格: | ¥4000.0 |
|---|---|---|---|
| 规格: | 25 μl | 产品价格: | ¥1700.0 |

Non-transfected (–) and transfected (+) 293T whole cell extracts (30 μg) were separated by 5% SDS-PAGE, and the membrane was blotted with CARD10 antibody [N2C1], Internal (GTX111222) diluted at 1:1000. The HRP-conjugated anti-rabbit IgG antibody (GTX213110-01) was used to detect the primary antibody.

Various whole cell extracts (30 μg) were separated by 5% SDS-PAGE, and the membrane was blotted with CARD10 antibody [N2C1], Internal (GTX111222) diluted at 1:3000. The HRP-conjugated anti-rabbit IgG antibody (GTX213110-01) was used to detect the primary antibody.

CARD10 antibody [N2C1], Internal detects CARD10 protein at cytoplasm on human breast carcinoma by immunohistochemical analysis.
Sample: Paraffin-embedded human breast carcinoma.
CARD10 antibody [N2C1], Internal (GTX111222) diluted at 1:250.
Antigen Retrieval: Trilogy™ (EDTA based, pH 8.0) buffer, 15min

Mouse tissue extract (50 μg) was separated by 5% SDS-PAGE, and the membrane was blotted with CARD10 antibody (GTX111222) diluted at 1:500. The HRP-conjugated anti-rabbit IgG antibody (GTX213110-01) was used to detect the primary antibody, and the signal was developed with Trident ECL plus-Enhanced.

Various whole cell extracts (30 μg) were separated by 7.5% SDS-PAGE, and the membrane was blotted with CARD10 antibody [N2C1], Internal (GTX111222) diluted at 1:1000. The HRP-conjugated anti-rabbit IgG antibody (GTX213110-01) was used to detect the primary antibody. Corresponding RNA expression data for the same cell lines are based on Human Protein Atlas program.

CARD10 antibody [N2C1], Internal detects CARD10 protein at cytoplasm by immunohistochemical analysis.
Sample: Paraffin-embedded mouse kidney.
CARD10 stained by CARD10 antibody [N2C1], Internal (GTX111222) diluted at 1:500.
Antigen Retrieval: Citrate buffer, pH 6.0, 15 min

Various whole cell extracts (30 μg) were separated by 7.5% SDS-PAGE, and the membrane was blotted with CARD10 antibody [N2C1], Internal (GTX111222) diluted at 1:1000. The HRP-conjugated anti-rabbit IgG antibody (GTX213110-01) was used to detect the primary antibody.
风险提示:丁香通仅作为第三方平台,为商家信息发布提供平台空间。用户咨询产品时请注意保护个人信息及财产安全,合理判断,谨慎选购商品,商家和用户对交易行为负责。对于医疗器械类产品,请先查证核实企业经营资质和医疗器械产品注册证情况。
 文献和实验
文献和实验Kahle JJ et al., Hum Mol Genet 2011 (PMID:21078624)
McAuley JR et al., Oncogene 2019 (PMID:31420608)
In the field of therapeutic recombinant proteins, monoclonal antibodies (mAbs) have achieved a rising success with more than 30 mAbs that have reached the market in the past 20 years. From a structural standpoint, one of the most important
. For most substrates, it is believed, though it has been demonstrated experimentally only for a few, that the first ubiquitin moiety is conjugated, via its C-terminal Gly76 residue, to an ε-NH2 group of an internal Lys residue. Recent findings indicate
Using MZEF to Find Internal Coding Exons
) was designed to help identify one of the most important classes of exons, i.e. the internal coding exons, in human genomic DNA sequences. It is neither for predicting intronless genes, nor for assembling predicted exons into complete gene models
 技术资料
技术资料暂无技术资料 索取技术资料

![ACSF2 antibody [AT18B4]](https://img1.dxycdn.com/2022/0328/896/5303267378450800453-14.jpg!wh200)
![Cytokeratin 13 antibody [MSVA-613M] HistoMAX](https://custom.dxycdn.com/trademd/upload/pic/2013/11/12/A1383891150.jpg!small.t.1)



